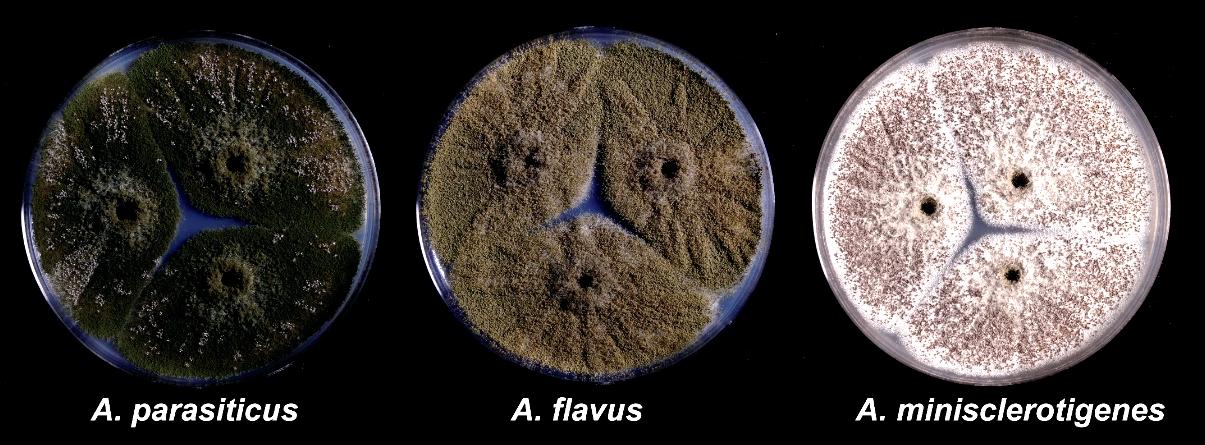
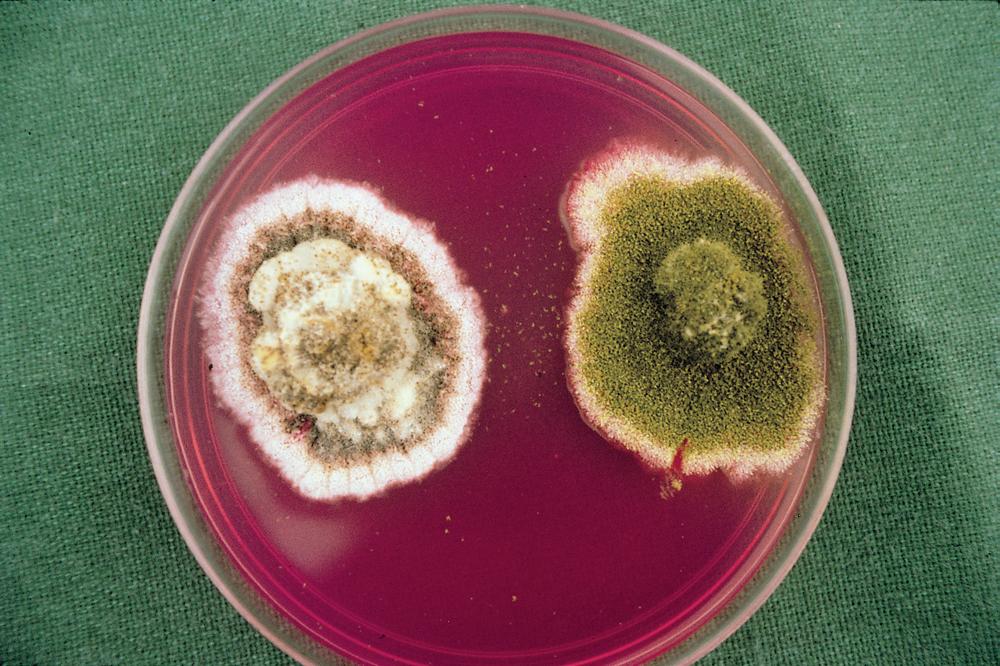
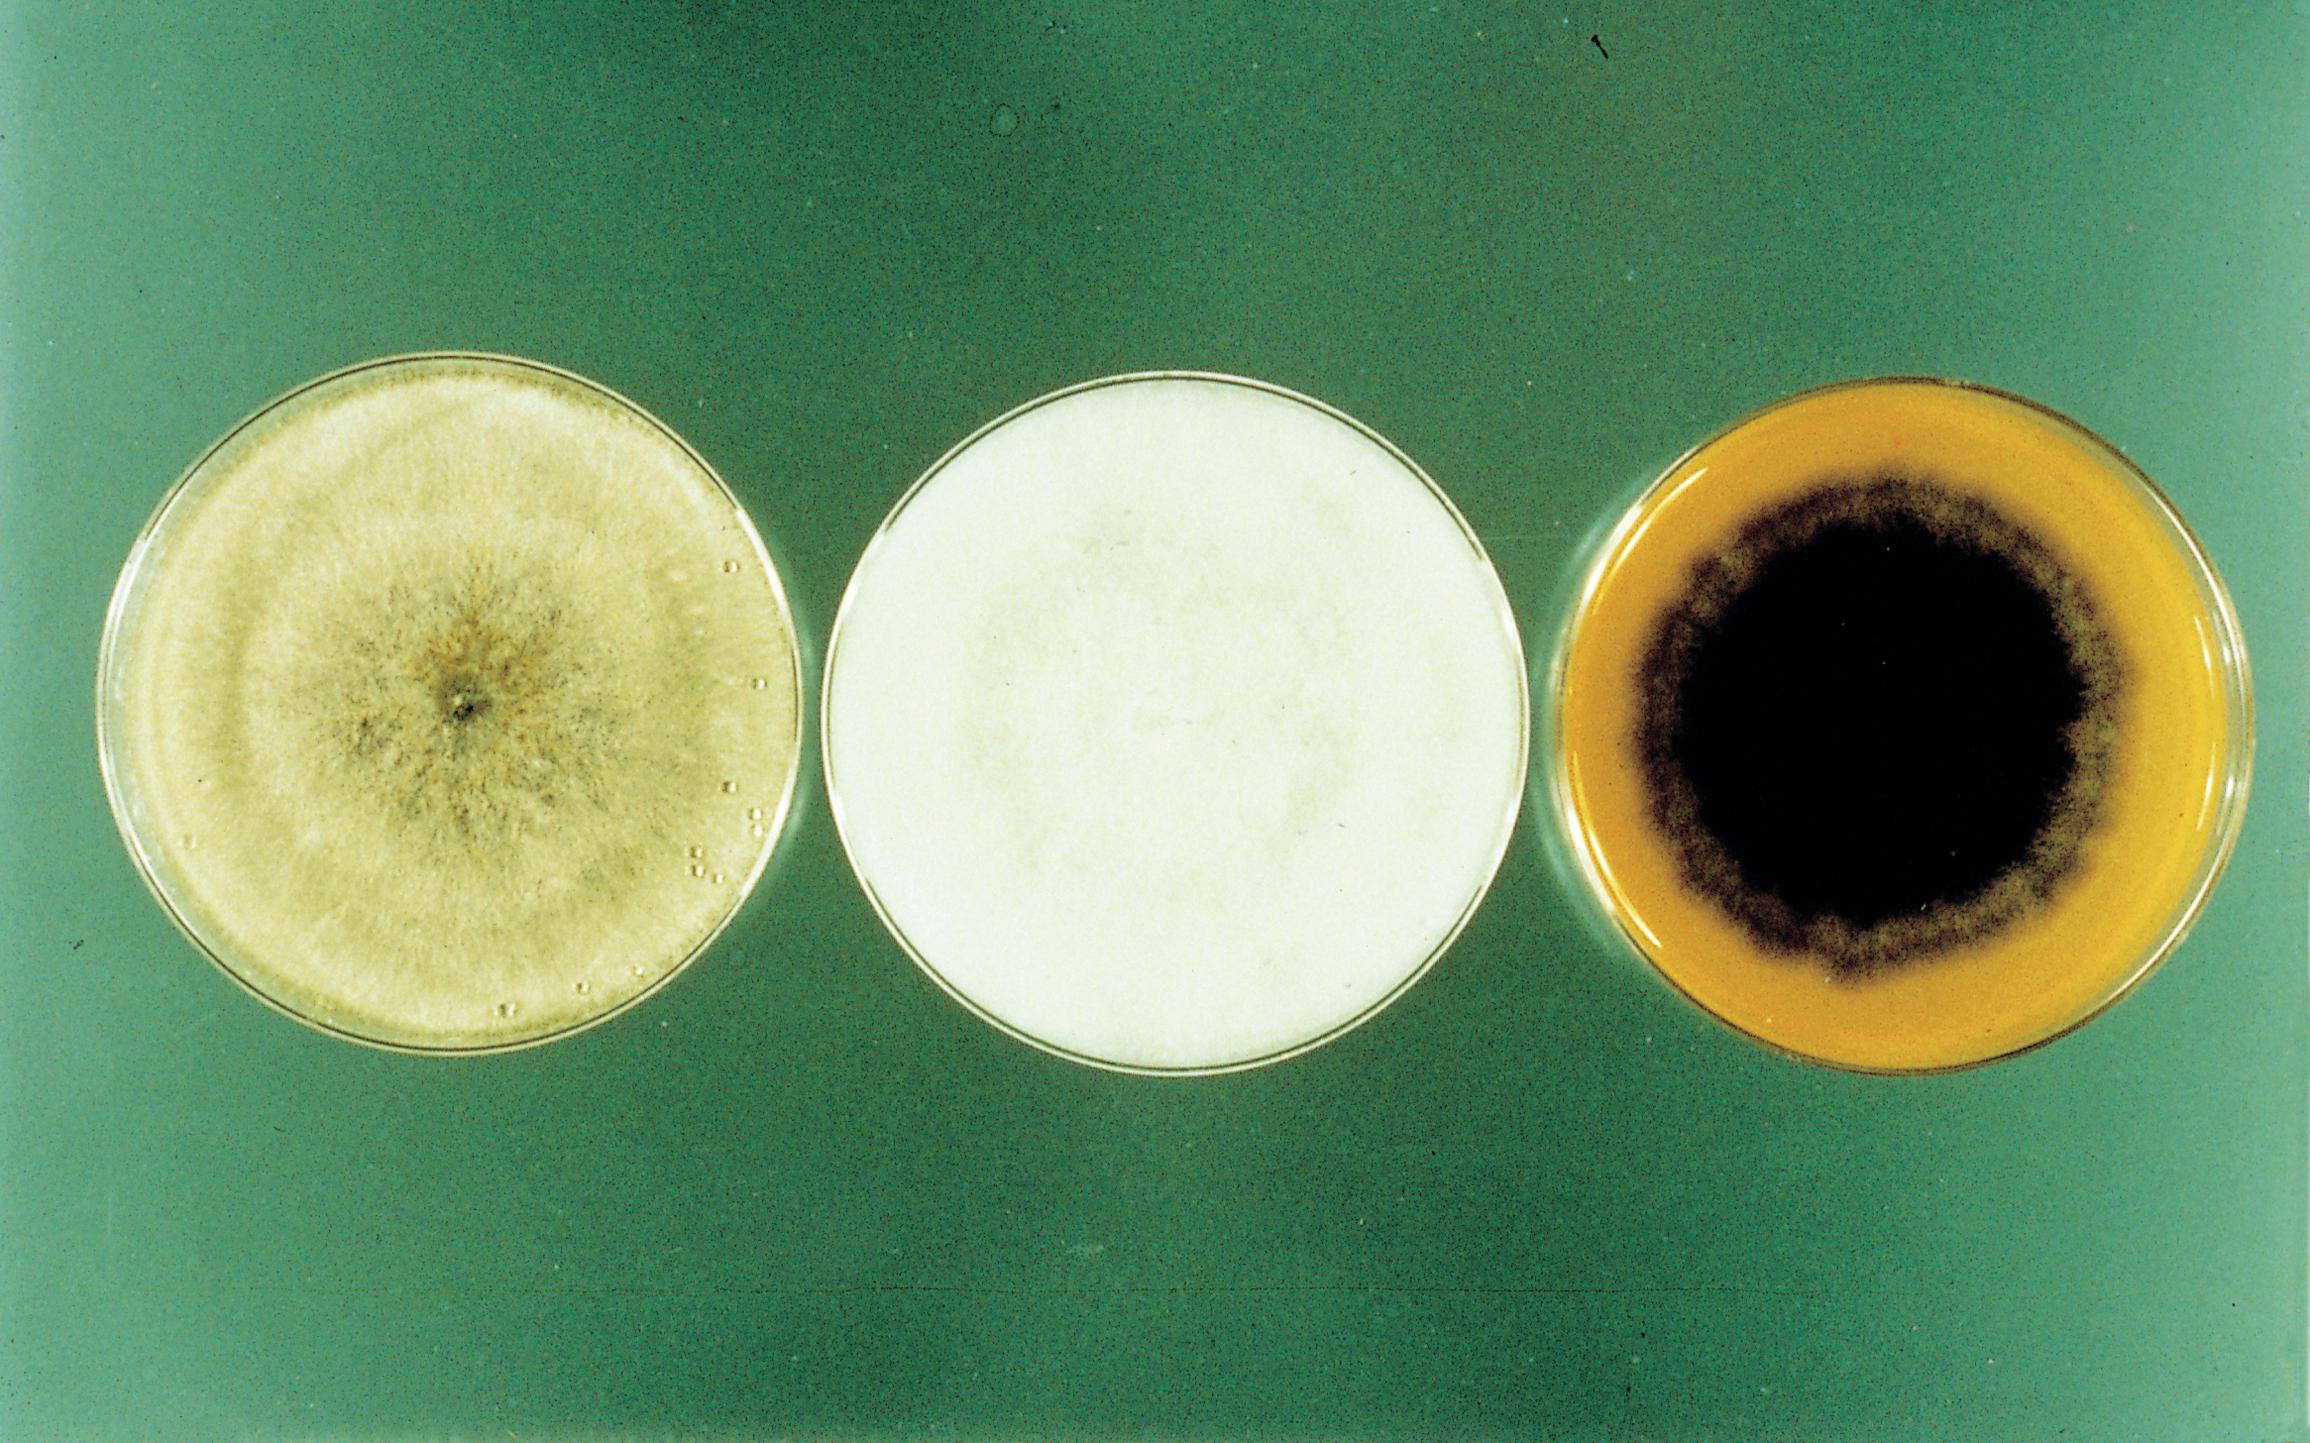

Compendium of Cotton Diseases and Pests
THIRD EDITION
Part I. Infectious Diseases
Cottonseed Losses and Mycotoxins
Seed contributes about 15% of farmer income from cotton. Dairies and oil mills compete for cottonseed for use as feedstock and oil production, respectively, and largely determine the ultimate seed price. If prices of competing commodities (i.e., corn [Zea mays]) are sufficiently high, cattle feedlots may also be important outlets for cottonseed. However, feed use of cottonseed and cottonseed meal is limited by the presence of the natural plant compound gossypol, which is particularly toxic to monogastric animals. Farmers can influence the value of seed sold to oil mills by selecting cultivars with large seed and high oil content. Trading rules permit seed lacking these characteristics to be discounted. Factors that influence lint yield also influence seed yield. However, there are two important characteristics that indicate seed quality and value that do not relate to lint value. These are free fatty acid content and the presence of aflatoxins.
Free Fatty Acid Content
Operators of oil mills have long known that cottonseed with high moisture will deteriorate in storage. Free fatty acids form when mature seed is exposed to high moisture; therefore, the free fatty acid content is the mostused measure of seed deterioration, although seed deterioration also refers to the breakdown of the cotyledon and embryo within the seed. Free fatty acid content is expressed as the percent of the extracted cottonseed oil that is composed of free fatty acids. Free fatty acids are formed when the constituent triglycerides in the oil break down. For oil mills, increased free fatty acid content results in reduced oil yield and increased refining costs. Oil mills, therefore, base prices for cottonseed in part on free fatty acid content. Oil mill seed discounts begin when seed contains greater than 1.8% free fatty acids in the oil. Discounts increase as fatty acid content increases. In addition to being used as a general indicator of seed deterioration, high free fatty acid content may be used as a criterion for rejection by other cottonseed consumers. Free fatty acid content is routinely determined in laboratories by extracting the oil from the cottonseed and then measuring oil acidity by titration.
All seed with a moisture content over 12% is assumed to be in the process of deteriorating. Unfortunately, in some seasons, all seed from an area may have a moisture content over 12% when harvested. Another indicator of preginning deterioration is bald seed (seed from which patches of the short fibers have been ripped during ginning). Bald seed results from microbial activity weakening fiber and linter attachment to the seed coat.
Formation
Free fatty acids form when mature seed is exposed to high moisture. Warm temperatures speed up the process, which may
be catalyzed by both plant and microbial enzymes. A wide range of fungi and bacteria contribute to seed deterioration. However, the term also refers to loss of seed reserves and seed viability independent of microbes. The process is considered to include all stages of seed germination, during which seed reserves (oil, protein, and sugar) are converted for use by the developing embryo. At an extreme, this includes vivipary (seed germination within the mature boll prior to harvest). Deterioration and formation of free fatty acids may occur in the field as the mature crop awaits harvest, in modules, and after ginning.
Management
Management practices that minimize canopy humidity, prompt harvest of a dry crop, and proper construction of modules can minimize cottonseed deterioration. Seed should never be put in modules when wet. Moist trash in modules increases seed moisture and deterioration. Unfortunately, the extent of deterioration is largely determined by the environment, and during very wet years, deterioration initiates prior to harvest. Postharvest use of mold inhibitors and preservatives to prevent seed deterioration has been investigated but has not been adopted for industrial use. To prevent deterioration, seed cotton should be harvested dry (moisture below 12%) and stored in covered carts or properly constructed covered modules (i.e., square or round bales). Modules should be built on well drained areas of the field. Cotton should be uniformly and tightly packed within a square module, and the bale should be covered with an undamaged module cover/tarp. Construction and wrapping of round modules are automated, but care should be taken to avoid dropping the module on stalks or other debris that can puncture or tear the plastic wrap. Harvested cotton should be ginned in a timely manner, especially if it is harvested wet or exposed to moisture during storage. After ginning, seed should be rapidly transported to storage facilities where it may be cooled, dried, and protected from further wetting. Cooling to temperatures below 16°C (60°F) stabilizes seed with excess moisture. Storage facilities should have adequate aeration to cool and dry the stored tonnage. Highmoisture seed should be fed or processed as rapidly as possible.
Aflatoxins
Aflatoxins are chemical compounds produced by certain fungi in the genus Aspergillus section Flavi. These fungal metabolites are toxic and can cause serious disease in animals, including livestock, as well as humans. The primary target of aflatoxins in animals is the liver. Aflatoxin B1, the most common aflatoxin, is known to induce cancer in some animals at concentrations as low as 1 part per billion (ppb = µg/kg). This makes aflatoxin B1 one of the most potent known carcinogens.
All cottongrowing regions may experience some aflatoxin contamination of cottonseed in some years. In most of the U.S. Cotton Belt, occurrence of unacceptable aflatoxin levels in cottonseed is uncommon. In Arizona, southern Texas, and the Imperial Valley of California, however, aflatoxins are a perennial concern.
Aflatoxins are transmitted from feed to the milk of dairy cows, and to minimize human exposure risk, milk may not have aflatoxin concentrations greater than 0.5 ppb. Consequently, feeding of cottonseed exceeding 20 ppb aflatoxin B1 to dairy cows is prohibited. Milk with excess aflatoxins is usually destroyed safely and the producing dairy put in quarantine. Since dairies typically pay a premium for cottonseed, in areas where aflatoxin contamination is common, aflatoxin content is the most important factor determining cottonseed value. Aflatoxins also cause losses when cottonseed is used for oil production. During processing, hulls and kernels are separated, and the kernels, which contain most of the aflatoxin, are physically disrupted. Oil is extracted, and the aflatoxins are concentrated in the solids (the meal). Thus, the meal may have almost twice the aflatoxin concentration as the intact seed. Meal with high aflatoxin levels must be used as fertilizer with a great reduction in value, and since the meal is a highprotein feed ingredient, it is an important source of income for mills. Consequently, it is important for oil mills to know the aflatoxin content of their seed at receipt so seed with varying levels of aflatoxin may be stored and processed separately. Hulls, which are also a common feed, may also contain unacceptable aflatoxin concentrations due to associated kernel fragments from highly contaminated seed.
Symptoms
A distinct symptom of seed lots contaminated with aflatoxins may be a brightgreenyellow fluorescence (BGYF) observed under ultraviolet light on the linters of a small subset of the seed (Fig. 10). Although aflatoxins also fluoresce, the compound causing BGYF is not an aflatoxin but is a highmolecularweight substance that forms when kojic acid (another fungal metabolite) reacts with cotton peroxidase. Little aflatoxin forms on the lint or hulls; almost all the aflatoxin is within the kernel. The presence of BGYF does not necessarily indicate a seed lot is contaminated with unacceptable aflatoxin levels, and absence of BGYF does not mean the crop has acceptable aflatoxin levels. A low percentage of the seed has BGYF even in highly contaminated lots, but higher frequencies of fluorescence may indicate greater levels of aflatoxin.
An exception to this may occur in areas where biocontrol products containing nonaflatoxigenic (atoxigenic) strains of Aspergillus flavus are used, since these are still able to produce BGYF. In such areas, BGYF has no relationship to aflatoxin content. In areas where atoxigenic strains are not used, seed

piles with greater than 0.5% of seed having BGYF will generally have unacceptable aflatoxin concentrations. BGYF may also be found on the lint from A. flavus infected bolls, even after ginning. This is sometimes called “cat eye.” Fiber with cat eye generally has acceptable spinning quality, and the fluorescence is readily removed from the resulting yarn and fabric during the scouring and bleaching processes that are normally used in dyeing and finishing.
Analytical tests to quantify aflatoxins are precise, but aflatoxin contamination is heterogeneous within the cotton crop. Therefore, results of analyses should be considered estimates. To make aflatoxin estimates as accurate as possible, careful sampling must be performed. The best sampling method relies on inline samplers that collect seed passing from gin stands at equal increments throughout the lot being sampled. Sampling alternatives include seedpile sampling with a 1.32m (52in.) coiled trier and truck sampling with vacuum probes. Individual seeds may contain over 500,000 ppb aflatoxin, and if one seed in 25,000 seeds is above 500,000 ppb aflatoxin, the sample will be unacceptable for dairy use. For analyses to be reliable, relatively large samples must be carefully taken from multiple locations within a seed pile or truck.
Some states mandate specific sampling schemes and assay procedures in commerce. Both public and private certified laboratories with the capacity to measure aflatoxin content of cottonseed exist in many states. These laboratories may perform either chromatographic or immunological analyses. Simple immunological tests approved by the Association of Official Analytical Collaboration (AOAC International) are available and suitable for use at gins, dairies, by wholesalers, and at oil mills. However, these tests still require careful sampling, decortification (removal of hulls and linters), kernel grinding, and toxin extraction. Failure to accurately measure aflatoxins can leave the gin and/or farmer vulnerable to litigation.
Causal Organisms
Only members of the genus Aspergillus section Flavi are known to contaminate cottonseed with aflatoxins. Over 90% of aflatoxin contamination of cottonseed in the United States is caused by A. flavus. However, in regions where other aflatoxin producers (i.e., A. parasiticus, A. nomius, A. minisclerotigenes, and several unnamed taxa) are common, these species may also infect and contaminate cottonseed. On Czapek’s agar, most aflatoxinproducing fungi form colonies (5–10 days at 30°C [86°F]) that appear yellow green to dark green due to profuse production of conidia (Fig. 11). Most A. flavus isolates produce lightgreen colonies with smooth conidia (3–6 µm) and only B aflatoxins; A. parasiticus produces generally darkergreen colonies, conidia (3.5–6.5 µm) with distinctly roughened (golf balllike) walls, and both B and G aflatoxins. A. nomius, which occurs relatively infrequently, produces colonies similar to those of A. flavus but is distinguishable from A. flavus by production of both B and G aflatoxins and slightly roughened conidia. Many aflatoxinproducing isolates produce sclerotia on Czapek’s agar, but even isolates within the species A. flavus vary widely in sclerotial size and shape and in the quantity of sclerotia produced. Some aflatoxinproducing species, including A. minisclerotigenes and certain isolates within A. flavus, produce few conidia and abundant small sclerotia.
Two distinct morphotypes of A. flavus infect and contaminate cottonseed in the United States. Cultures of A. flavus isolates of the typical L strain morphotype produce abundant quantities of conidia and relatively few large (>400 µm) sclerotia. The S strain morphotype typically produces fewer conidia than the L strain morphotype and profuse quantities of small (<400 µm) sclerotia. L strain isolates produce variable quantities of aflatoxins (in some cases, none), whereas S strain isolates typically produce high concentrations of aflatoxins. Colonies of S strain isolates growing from cottonseed may initially appear white and fluffy with few or no mature conidiophores (Fig. 12). In 5–7
Fig. 10. Bright- green-yellow fluorescence (BGYF) on cottonseed as observed under ultraviolet light. (Cour tesy P. J. Cotty)

12. Fungal isolation on modified rose bengal agar from cottonseed infected with S (left) and L strain (right) isolates of Aspergillus flavus. The black coloration of the S strain isolate is from melanized sclerotia, and the green coloration of the L strain isolate is from green conidia. (Cour tesy P. J. Cotty)
days, regions of the white colony mature into tiny, black sclerotia typically interspersed with conidial heads, which can be observed with a dissecting microscope. In some western desert valleys of the United States, S strain isolates compose over 50% of the A. flavus community. In other regions, crops are frequently infected by aflatoxin producers with S strain morphology, though these are sufficiently divergent from A. flavus to be considered a distinct species.
A. flavus is a highly variable fungus. Each morphotype is composed of many genetic groups or vegetative compatibility groups that vary greatly in aflatoxinproducing ability. S strain isolates, on average, produce much higher concentrations of aflatoxins than L strain isolates that, in some cases, produce no aflatoxins. Isolate variability contributes to variability in crop aflatoxin content. Thus, identification of the specific etiologic agent(s) of contamination may be difficult. For example, the S strain may account for only a minor proportion of infections, but, due to its high aflatoxinproducing potential, it may be the primary cause of high levels of aflatoxins in cottonseed.
Disease Cycle and Epidemiology
Aspergillus spp. are ubiquitous in the environment and survive as saprophytes in soils and on crop debris. Aflatoxinproducing fungi occur in all agricultural soils where cotton is produced, but larger overall populations are present in warmer regions where they can outcompete other microbes in both the soil and on the crop. A. flavus utilizes a wide range of organic substrates and may act as an opportunistic pathogen of plants, insects, and mammals. The fungus survives between seasons
as free conidia, sclerotia, as mycelia in crop debris, and in association with insects. Wind, rain, and insects disperse the fungus to the crop. Movement onto the crop is favored when the environment is conducive for growth and sporulation (high temperatures and humidity). Cottonseed is most susceptible to fungal infection when developing bolls are wounded or when open bolls are exposed to both high humidity and warm temperatures. Aflatoxin contamination of cottonseed occurs in two phases: 1) during crop development, and 2) following maturity of the crop.
The first phase of aflatoxin contamination is associated with physical damage to the crop, which may include insect damage or physiological stress due to hot, dry conditions. Wounds or cracks allow A. flavus to infect the developing bolls. The best documented infection ports are pink bollworm exit holes. However, any wound to the developing boll may be sufficient to permit A. flavus infection. Suture cracks and nectaries have also been suggested as possible entry points. Bolls infected by A. flavus through wounds prior to boll opening may produce seed with fluorescent staining (BGYF) on the lint and linters. Seed from these bolls, usually with linter BGYF, may contain extremely high aflatoxin concentrations, sometimes more than 500,000 ppb. Consequently, in some years, seed infected during this first phase contains most of the aflatoxin. However, even if only relatively low levels of contamination occur during the first phase, infections initiated prior to boll maturity will greatly influence the potential for aflatoxin to increase during the second phase. Bolls heavily infected by fungi before “fluffing out” tend to produce one or more “tight locks.” These are locules that do not fully fluff and are inefficiently picked by spindle pickers, which is partially responsible for generally lower aflatoxin content in spindlepicked cotton compared to cotton picked with a stripper or a rood (i.e., groundgleaned cotton).
The second phase of aflatoxin contamination occurs when mature crops are exposed to high moisture and warm temperatures either before or after harvest. This phase is characterized by increases in aflatoxin content of seeds infected during the first phase as well as new infections. Because cotton has an indeterminate growth habit, it can have developing bolls and mature bolls on the same plant. Thus, both phases of contamination may occur simultaneously. A. flavus colonizes tissues most readily and is most competitive against other microbes at temperatures above 30°C (86°F), and it continues to grow at temperatures up to 42°C (108°F). Severe aflatoxin contamination occurs when high nighttime temperatures (above 24°C [75°F]) coincide with exposure of the crop to high moisture following boll maturation. In the field, this may occur due to rain, irrigation, or high humidity. In warm areas like the desert valleys of Arizona and southern Texas, cottonseed aflatoxin content is highly correlated with the quantity of rain on the crop after initial boll opening. In these areas, crop surfaces become
Fig. 11. Cultures of some aflatoxin- producing Aspergillus section Flavi spp. grown on Czapek’s agar. (Cour tesy L. A. Maxwell)
Fig.
coated with A. flavus, and if seed moisture exceeds 15%, seed infection may proceed. Seed infected during this phase often does not exhibit BGYF on either the linters or lint. Increases in aflatoxin associated with the second phase of contamination may occur before and after harvest, including in storage modules, seed piles, and in the hands of the end user.
Management
To protect cotton from the crop development stage through its end use, aflatoxin management measures must address both phases of contamination. Management should target both the process and the causal agents of contamination. There are three main approaches to managing aflatoxin contamination: 1) reduce host susceptibility to contamination, 2) minimize crop exposure to environmental conditions that are conducive to contamination, and 3) reduce the aflatoxinproducing potential of fungi associated with the crop.
Several agronomic practices can reduce the susceptibility of the developing cotton crop to infection by A. flavus and aflatoxin contamination. Minimizing drought stress during crop development through proper irrigation can reduce aflatoxin contamination risk, but irrigation following boll maturation can create an environment that favors aflatoxin production. Preventing insect damage to developing bolls either by using insecticides or by planting insectresistant cultivars will help minimize boll infection during the first phase of contamination.
Minimizing crop exposure to environmental conditions that are conducive to contamination is especially important following boll maturation and postharvest. Practices that reduce humidity in the canopy, such as selecting cultivars with open canopies, managing fertility to minimize excessive or rank vegetative growth, and avoiding excessive irrigation, can reduce the second phase of contamination. Irrigation should be terminated as early as possible since late irrigations expose opening bolls to high humidity. In areas where irrigation is only supplemental, the soil water profile should be filled before initial boll opening and then irrigation should be terminated. The crop should be harvested as promptly as possible to prevent rewetting of open bolls by rain and dew. Both lint and seed quality deteriorate and aflatoxin content increases if either harvest or ginning are delayed. Environmental conditions conducive to contamination can overcome even the best management practices for minimizing aflatoxins in some seasons. In these situations, only the use of atoxigenic biological control agents (see below) can reduce contamination.
Gins can optimize the number of cottonseed lots with acceptable aflatoxin levels and influence the average cottonseed price by segregating the crop prior to ginning. Harvest date and rain on the crop after boll opening influence aflatoxin content. Earlyharvested cottonseed will have the least amount of aflatoxins, and crops receiving rain during warm periods after boll opening will have the most. Because of the great heterogeneity in aflatoxin content among fields, segregating seed on a fieldbyfield basis, especially early in the ginning season, will result in more lots with acceptable aflatoxin content and prevent contaminated seed from degrading seed that would otherwise sell at a premium. Spindlepicked cotton should be segregated and ginned separately. Rood harvesters collect cotton from the ground. This cotton is dirty and difficult to gin and is exposed to both the pathogen and moisture on the soil. Seed from a Rood cotton harvester should be kept separate, as this seed will generally have much higher aflatoxin contamination levels. Following harvest, measures must be taken to reduce or prevent moisture in the crop. As described above for minimizing seed deterioration, proper modules (square or round bales) should be formed with dry seed cotton, and modules should be covered. Aflatoxin concentrations increase with the length of module storage, so storage in modules should be limited to less than 1 week. Trash, especially leaves and stems, is a source of both fungi and moisture. Aflatoxin levels will morereadily
increase in modules with higher trash content. Seed should also be kept dry during transport and on site at dairy storage facilities to prevent increases in aflatoxin concentrations.
In some regions, the most consistent approach to managing aflatoxins in cottonseed both pre and postharvest is to modify the crop associated fungal community to reduce its aflatoxinproducing potential. This is accomplished through applying strains of A. flavus that do not produce aflatoxins (atoxigenic strains). These strains are usually applied as a granular product under the canopy on the soil surface prior to initial boll opening. Following irrigation or a rain event, the atoxigenic A. flavus strain grows and sporulates on the granular formulation (Fig. 13) and spreads to the crop. The atoxigenic strain competitively excludes aflatoxinproducing strains and reduces aflatoxin contamination during both phases of contamination.
Detoxification
Once aflatoxin contamination has occurred, several options remain for using the seed. Cottonseed with aflatoxin concentrations greater than 20 ppb cannot be used as dairy feed, but if the aflatoxin concentration is less than 300 ppb, it may be fed to mature beef cattle. In general, cottonseed with unacceptable aflatoxin levels may not legally be mixed with clean seed with the intent of reducing the aflatoxin content to acceptable levels. All cottonseed may be sold to an oil mill, which will remove the oil and sell the meal according to its aflatoxin content. In some states, an additional alternative is detoxification.
Aflatoxin contaminated commodities are detoxified by ammoniation in several regions of the world, and importation and use of meal detoxified by ammoniation is allowed by many countries. In Arizona and southern California, ammoniation is routinely used to detoxify aflatoxin contaminated cottonseed. However, the ammoniation process is not approved by the U.S. Food and Drug Administration, and as such, cottonseed products detoxified by ammoniation may not be shipped across state lines. Two general ammoniation processes are permitted: 1) a lowpressure technique (Arizona only) in which cottonseed is sprayed with water and anhydrous ammonia and either tarped or packed into silage bags, and 2) a highpressure technique in which seed is exposed to ammonia in a highpressure vessel. The lowpressure technique is commonly used at gins, feedlots, and dairies, while the highpressure technique generally involves shipping the seed to a processor. The cost of ammoniation is somewhat high. In addition to the ammoniation process itself, transportation fees and the fact that ammoniated

Fig. 13. A commercial biocontrol product of a nonaflatoxigenic (atoxigenic) strain sporulates on the applied substrate (sorghum grain) and moves onto the cotton crop where it displaces aflatoxin- producing fungi, thereby reducing aflatoxin contamination in cottonseed. (Cour tesy K. A. Callicott)
cottonseed is frequently traded at a discount must be considered. After ammoniation, seed should be stored carefully and utilized rapidly because, in environments where contaminated cottonseed is produced and handled, A. flavus spores can rapidly cover most surfaces, and the seed may be exposed to the fungus after removal from the ammoniation vessel. Because ammoniation increases seed moisture, the seed remains vulnerable to subsequent contamination.
Other Toxins
Fusarium spp. commonly infect cottonseed, and Fusarium mycotoxins are occasionally detected in cottonseed. However, aflatoxins are the only mycotoxins currently regulated in cottonseed. As of 2022, cottonseed contaminated with other mycotoxins has not been clearly implicated in incidences of livestock toxicity, but such potential exists, and cottonseed producers have suffered litigation over alleged toxicity to dairy cows from cottonseed infected with Fusarium spp. Such problems are most likely to occur when harvest is severely delayed, causing the crop to be exposed to prolonged weathering or even overwintering in the field. Seed from such crops should be identified at market and sold “as is.”
Animal nutritionists are aware that most cottonseed carries a level of natural toxicity due to high concentrations of gossypol. Because cottonseed may be blended with other feed ingredients and may deteriorate after shipping, gins and seed brokers may wish to retain samples of cottonseed sold to dairies to guard against litigation stemming from alleged feed toxicity or poor feed utilization. If litigation should arise, such samples may be used to establish cottonseed quality at the time of purchase and shipping. These cottonseed samples should consist of multiple subsamples taken according to a published protocol, such as the one established for aflatoxin sampling by the state of Arizona in its Commercial Feed Law. Only dry (moisture less than 12%) seed should be sampled, and samples should be stored dry in a sealed, watertight container, such as an FDAapproved 19L (5gal.) high densitypolyethylene pail. Samples should be held for a minimum of 1 year.
Planting Seed
The most profitable cottonseed market is for planting seed. Farmers and gins receive premiums by producing seed for seed companies. To qualify, seed must meet specific criteria. Prominent among seed company criteria is the free fatty acid content. A free fatty acid content below 0.5% is preferred, and a free fatty acid content above 1% is generally unacceptable for planting seed. This general measure of seed quality provides some assurance that the seed retains food reserves and will store well and produce vigorous seedlings. Failure to qualify means the seed must be sold on the open market.
Seed companies also section seed (known as “cut tests”) to examine internal seed morphology. Discoloration or deterioration of cotyledons or embryos may also lead to a seed lot being rejected. Other important criteria include maturity (based on seed coat color and seed and embryo size) and seed damage. Immature seed in excess of 20% and damaged seed in excess
of 15% will generally lead to the seed being rejected. After acid delinting, both these categories of seed must be determined by the seed companies, which results in an inconvenience and additional expense.
Phytosanitary certificates are required by some countries for the absence of Colletotrichum gossypii (syn. Glomerella gossypii), and seed from fields exhibiting anthracnose symptoms may be rejected by seed companies producing seed for export. Similarly, fields with bacterial blight may be excluded due to domestic restrictions on movement of seed contaminated with Xanthomonas citri subsp. malvacearum. Seed may also be rejected by seed companies based on weed seed content, moisture more than 10%, poor germination, and excessive trash content.
Optimizing planting seed quality begins with reducing exposure of the mature crop to humidity prior to harvest. Many of the recommendations listed under aflatoxin management may be useful in optimizing the quality of planting seed. Planting seed should be harvested dry (moisture less than 11%) and as early as possible. To reduce the percentage of immature seed, the crop may be harvested twice. For the first harvest, spindle pickers should be set to pick only fully fluffed bolls. This harvest may be completed before chemical boll openers have acted on lessmature bolls. Proper module construction and timely ginning can further optimize plantingseed quality. Module temperature should be monitored, and if temperatures do not stabilize (preferably below 32°C [90°F]) within 1 week, the seed cotton should be ginned immediately. Seed should not be stored for planting unless the moisture content is below 11%. Storage should follow the recommendations discussed in the previous section on managing the free fatty acids content.
Aflatoxins are not a concern for planting seed. However, during processing, immature, damaged, and lightweight seed are removed from seed batches intended for planting. These culls are sold to seed brokers who market the seed to oil mills, feedlots, and dairies. Aflatoxins survive the sorting process and may be at higher concentrations in the culls than in presorted seed. Thus, aflatoxins in culls may be a concern in regions even where high aflatoxin concentrations in unsorted seed are rare. The use of cull seeds at dairies has resulted in contaminated milk, leading to milk destruction and dairy quarantine.
Selected References
Anonymous. 2013. Trading rules. Page 209 in: National Cottonseed Products Association, Tucson, Arizona.
Conkerton, E. J., Schneider, G. R., and Bland, J. M. 1989. Prevention of deterioration of cottonseed in the field and during storage. Oil Mill Gazet. 95:34–38.
Cotty, P. J., Probst, C., and Jaime Garcia, R. 2008. Etiology and management of aflatoxin contamination. Pages 287–299 in: Mycotoxins: Detection Methods, Management, Public Health and Agricultural Trade. J. F. Leslie, R. Bandyopadhyay, and A. Visconti, eds. Oxfordshire, CABI.
Frisvad, J. C., Hubka, V., Ezekiel, C. N., Hong, S.B., Nováková, A., Chen, A. J., Arzanlou, M., Larsen, T. O., Sklená ř, F., Mahakarnchanakul, W., Samson, R. A., and Houbraken, J. 2019. Taxonomy of Aspergillus section Flavi and their production of aflatoxins, ochratoxins and other mycotoxins. Stud. Mycol. 93:1–63.
Park, D. L., and Pohland, A. E. 1989. Sampling and sample preparation for detection and quantitation of natural toxicants in food and feed. J. Assoc. Off. Anal. Chem. 72:399–404.
(Prepared by P. J. Cotty; revised by H. L. Mehl and P. J. Cotty)
Seedling Diseases
Seedling diseases are a major factor affecting cotton stand establishment and production worldwide. Cotton production loss estimates for the United States due to seedling diseases over a recent 20 year period (2001–2019) averaged 1.9%, even with the use of fungicide seed treatments (National Cotton Council Disease Database). Seedling diseases refer to a group of diseases caused by several soilborne and seedborne pathogens. Losses in any one year and location are strongly affected by the environment shortly after planting, including soil moisture and temperature, and by the occurrence and population density of these pathogens. Although we now have a better understanding of how to manage seedling diseases, their importance in cotton production losses still ranks high.
A number of different symptoms may be associated with seedling diseases. Acute disease symptoms include seed decay, death of the seedling prior to emergence (pre emergence damping off), and death of the seedling after emergence (postemergence damping off). Acute symptoms result in lower plant populations and reduced stand uniformity that may cause management problems for crop development (delayed maturity) and weed and insect management, negatively affecting yield (Fig. 14). Severe stand losses may require replanting, resulting in additional input costs, delayed stand establishment, and potential yield reductions. Seedling diseases also cause chronic lesions on the hypocotyl and root rot or pruning that reduce growth and delay crop development.
The importance of the environment on seedling diseases and cotton stand establishment is widely recognized. A standardized fungicide seed treatment trial, conducted by cooperators in the Cotton Disease Council, across the Cotton Belt in the United States found that the average difference in stand establishment was 13.2% across all environments where fungicidetreated seed were used in comparison to untreated seed. Stand differences increased dramatically as temperature after planting decreased, particularly at lower temperatures, and with increasing rainfall the first few days after planting (Fig. 15).
Seedling pathogens act alone or in combination to cause a range of symptoms. It is often difficult to establish the primary causal agent in field diagnoses since most soils contain several of these pathogens. Isolations of microorganisms from diseased seedlings often include multiple pathogens and saprophytes whose combined activities result in disease symptoms. Thus, in most situations, a complex of seedling pathogens exists. How


Fig. 15. Difference in mean stand percentages between seed treated with a triazole and either metalaxyl or mefenoxam and seed with no fungicide treatment for trials from 1999 to 2004 in relation to rainfall and average minimal soil temperature for the first 3 days after planting. (Cour tesy Rothrock et al., 2012— © APS)
ever, symptoms can suggest the causal agents, and in combination with field history, environment, and laboratory isolation, the primary causal pathogen or pathogens can be determined.
The primary agents of seedling diseases worldwide are Globisporangium and Pythium spp. (oomycetes), Rhizoctonia solani (syn. Thanatephorus cucumeris), Fusarium spp., and Berkeleyomyces basicola (syns. Thielaviopsis basicola, Chalara elegans). All of these pathogens are ubiquitous in cotton soils except B. basicola. Soil populations may be associated with the level of damage but often explain only a small portion of the variability in stands observed across fields.
Other pests, especially several nematode species that are important in cotton production, can cause an increased susceptibility to seedling pathogens, resulting in seedling death (see Nematode–Fungal Interactions).
Selected References
Colyer, P. D., and Vernon, P. R. 2005. Impact of stale seedbed production on seedling diseases of cotton. Plant Dis. 89:744–748.
Davis, R. M., Nunez, J. J., and Subbarao, K. V. 1997. Benefits of cotton seed treatments for the control of seedling diseases in relation to inoculum densities of Pythium species and Rhizoctonia solani. Plant Dis. 81:766–768.
Pullman, G. S., DeVay, J. E., Garber, R. H., and Weinhold, A. R. 1981. Soil solarization: Effects on Verticillium wilt of cotton and soilborne populations of Verticillium dahliae, Pythium spp., Rhizoctonia solani, and Thielaviopsis basicola. Phytopathology 71:954–959. Rothrock, C. S., Winters, S. A., Miller, P. K., Gbur, E., Verhalen, L. M., Greenhagen, B. E., Isakeit, T. S., Batson, W. E., Jr., Bourland, F. M., Colyer, P. D., Wheeler, T. A., Kaufman, H. W., Sciumbato, G. L., Thaxton, P. M., Lawrence, K. S., Gazaway, W. S., Chambers, A. Y., Newman, M. A., Kirkpatrick, T. L., Barham, J. D., Phipps, P. M., Shokes, F. M., Littlefield, L. J., Padgett, G. B., Hutmacher, R. B., Davis, R. M., Kemerait, R. C., Sumner, D. R., Seebold, K. W., Jr., Mueller, J. D., and Garber, R. H. 2012. Importance of fungicide seed treatment and environment on seedling diseases of cotton. Plant Dis. 96:1805–1817.
Wheeler, T. A., Gannaway, J. R., Kaufman, H. W., Dever, J. K., Mertley, J. C., and Keeling, J. W. 1997. Influence of tillage, seed quality, and fungicide seed treatments on cotton emergence and yield. J. Prod. Agric. 10:394–400.
(Prepared by J. E. DeVay; revised by C. S. Rothrock)
Fig. 14. Lack of stand uniformity as a result of seedling diseases. (Cour tesy T. L. Kirkpatrick— © APS)
Diseases Caused by Globisporangium and Pythium
Species
Seedling diseases caused by Pythium spp., many of which are now placed in the genus Globisporangium, are widespread in cottongrowing areas worldwide. Although members of the genera Globisporangium and Pythium have a filamentous growth habit like fungi, these oomycetes are classified in the supergroup Chromalveolata (syn. Stramenopila) and are moreclosely related to some groups of algae. The most common symptoms associated with Globisporangium and Pythium spp. are seed rot and preemergence dampingoff, resulting in stand losses. A significant negative correlation has been found between the percentage of seedlings from which these pathogens were isolated and percent emergence of seedlings. In addition, stand responses from the use of oomyceteselective fungicide seed treatments have demonstrated the widespread and frequent importance of Globisporangium and Pythium spp. in stand establishment. Seedling diseases caused by Globisporangium and Pythium spp. are of particular significance in fields where the minimal soil temperature at planting is 20°C (68°F) or lower with rainfall the first few days after planting (Fig. 16). Substantial stand reductions may require replanting.
Symptoms
Under favorable environmental conditions for disease, infection of cotton seed by Globisporangium and Pythium spp. can occur within hours after planting. Colonization results in disintegration of the tissue, resulting in a soft rot of the seed. If germination occurs, the developing radical may be colonized, resulting in the death of the developing seedling. Colonization of the developing seedling may cause tan to brown lesions on the radicle and hypocotyl with a soft, watery appearance and texture when squeezed (Fig. 17). In some situations, these lesions may result in postemergence dampingoff. Globisporangium and Pythium spp. also may severely reduce seedling root development with little discoloration, suggesting that limited root growth is also a symptom of damage by these pathogens. Oospores may be present in plant tissue, and sporangia and zoospores may form after placing affected tissue in water overnight. Globisporangium and Pythium spp. are readily isolated from seed, roots, and hypocotyl lesions by placing disinfested sections of seedlings on lownutrient media, such as water agar, or on corn meal agar amended with antibiotics and incubating for 1–3 days. Several semiselective media are available for oomycetes. Globisporangium and Pythium spp. generally grow rapidly from tissue with a white, appressed or fluffy growth on media and may exhibit an annular or rosette growth pattern (Fig. 18).

Causal Organisms
Several species of Globisporangium and Pythium have been reported to be part of the cotton seedling disease complex, including G ultimum (syn. P. ultimum), G. irregulare (syn. P. irregulare), G sylvaticum (syn. P. sylvaticum), G. heterothallicum (syn. P. heterothallicum), G intermedium (syn. P. intermedium), and P aphanidermatum. Cotton seedlings may be infected by several different Globisporangium and/or Pythium spp. at a time. No recent survey of Globisporangium and Pythium spp. involved in the seedling disease complex using molecular techniques has been conducted. In other crops, such survey methods have identified a muchgreater species diversity than that currently reported on cotton. However, the biology and management strategies of uncharacterized species should be similar.
Globisporangium and Pythium spp. are characterized as fastgrowing, white, odorless colonies with robust, nonseptate hyphae 6–11 µm in diameter. Asexual and sexual structures are important in morphological identification of species. The shape of the sporangia, an asexual structure, the occurrence and ornamentation of the oogonia and antheridia, and the size of oospores are diagnostic. Sporangia may be filamentous, inflated or not, or globose. Oogonia may be smooth walled or ornamented, and antheridia number and shape vary. Several species may produce globose hyphal swellings. Asexual reproduction is via motile zoospores released from a vesicle attached to the sporangium. Sexual reproduction is by oospores that form when oogonia are fertilized by antheridia. To observe sexual structures, media must contain sterols. Sporangia and zoospores can be observed in axenic cultures on floating grass blades in water. Some species are homothallic, while other species are heterothallic, needing isolates of two mating types to form oospores.
G. ultimum forms globose, mostly terminal oogonia. Antheridia are mostly on the same hypha, monoclinous, arising close to the oogonium, and the resulting oospore does not fill the oogonium (aplerotic). G. irregulare has irregularly shaped oogonia with blunt, irregular projections often forming in the middle of hyphae, intercalary, with antheridia being monoclinous, originating some distance from the oogonium. P. aphanidermatum produces globose, terminal oogonia that are fertilized by mostly intercalary, saccate antheridia to form aplerotic oospores. Sporangia also differ among species, with G. irregulare producing sporangia and hyphal swellings that are globose and terminal or intercalary, while P. aphanidermatum produces irregularly terminal, swollen hyphal sporangia. G. sylvaticum, G. heterothallicum, and G. intermedium are heterothallic and produce numerous terminal hyphal swellings.

Fig. 16. Difference in mean stand percentages between seed with a selective fungicide treatment against oomycetes in relation to rainfall and average minimal soil temperature for the first 3 days after planting. (Cour tesy Rothrock et al., 2012— © APS)
Fig. 17. Soft rot symptoms associated with Globisporangium and Pythium spp. (Cour tesy C. S. Rothrock— © APS)
Disease Cycle and Epidemiology
The primary survival structures of Globisporangium and Pythium spp. are oospores, either free in the soil or embedded in plant residue, or globose hyphal swellings in some species. Germination is stimulated by exudates from germinating seeds or seedling roots. As a result of rapid germination and growth or taxis of zoospores, these pathogens avoid antagonism by most microorganisms near the seed or seedling prior to contact with the host and infection. Globisporangium and Pythium spp. form oospores, hyphal swellings, or sporangia in the colonized tissue. Zoospores and sporangia are generally short lived, hours to days, but may serve as inoculum to increase disease by secondary infections or from recently colonized organic material.
Globisporangium and Pythium spp. are known to infect immature or succulent tissue; thus, damage may be limited in older plants. However, damage by these pathogens may continue on juvenile tissues, such as root tips, causing root pruning and allowing disease and reproduction to continue throughout the season under favorable conditions.
Seedling diseases caused by Globisporangium and Pythium spp. are more important in cool, wet environments (Fig. 16); however, these pathogens have a range of temperature preferences (i.e., P. aphanidermatum may also be damaging at high temperatures). Seedling diseases caused by Globisporangium and Pythium spp. are more associated with soils having higher clay content than in well drained, sandy soils. Based on results from some research, there is a correlation between soil population densities of these pathogens and stand losses or disease symptoms.
Globisporangium and Pythium spp. are pioneer colonizers of fresh plant tissue and other organic material incorporated into soils. Incorporating cover crops, weeds, or other organic materials prior to planting has the potential to increase population densities of Globisporangium and Pythium spp. and disease pressure. In addition to survival as oospores and colonizing organic material, these pathogens also survive as parasites on numerous crop and weed species, which may show no evidence of damage.
Management
Resistance to Globisporangium and Pythium spp. among cotton cultivars is low, but some variability has been reported. Because of low resistance levels available in cotton, management strategies have focused on agronomic practices, including the use of high quality seed, delaying planting until after minimal soil temperatures reach 20°C (68°F), planting on raised seed beds to increase soil temperature and improve drainage, and a favorable weather forecast following planting. Fungicides with specific activity against oomycetes should be part of any fungicide combination applied to seed. Additional fungicide products or amounts can be applied as custom seed treatments or infurrow treatments in situations favorable for seedling diseases caused by these pathogens.
Selected References
DeVay, J. E., Garber, R. H., and Matheron, D. 1982. Role of Pythium species in the seedling disease complex of cotton in California. Plant Dis. 66:151–154.
Hillocks, R. J. 1992. Seedling diseases. Pages 13–17 in: Cotton Diseases. R. J. Hillocks, ed. CAB International, Wallingford, UK. Johnson, L. F., and Chambers, A. Y. 1973. Isolation and identity of three species of Pythium that cause cotton seedling blight. Plant Dis. Rep. 57:848–852.
Johnson, L. F., and Doyle, J. H. 1986. Relationship of seedling diseases of cotton to characteristics of loessial soils in Tennessee. Phytopathology 76:286–290.
Nelson, E. B., and Craft, C. M. 1989. Comparative germination of culture produced and plantproduced sporangia of Pythium ultimum in response to soluble seed exudates and exudate components. Phytopathology 79:1009–1013.
Rothrock, C. S., Winters, S. A., Miller, P. K., Gbur, E., Verhalen, L. M., Greenhagen, B. E., Isakeit, T. S., Batson, W. E., Jr., Bourland, F. M., Colyer, P. D., Wheeler, T. A., Kaufman, H. W., Sciumbato, G. L., Thaxton, P. M., Lawrence, K. S., Gazaway, W. S., Chambers, A. Y., Newman, M. A., Kirkpatrick, T. L., Barham, J. D., Phipps, P. M., Shokes, F. M., Littlefield, L. J., Padgett, G. B., Hutmacher, R. B., Davis, R. M., Kemerait, R. C., Sumner, D. R., Seebold, K. W., Jr., Mueller, J. D., and Garber, R. H. 2012. Importance of fungicide
Fig. 18. Colony appearance of Rhizoctonia solani (left), a Pythium - like sp. (middle), and Berkeleyomyces basicola (right). (Cour tesy C. S. Rothrock— © APS)